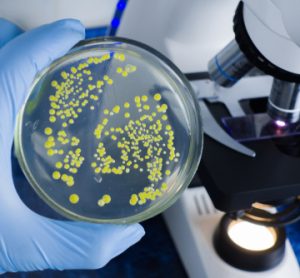
A scientist's gloved hand holding a petri dish showing microbial cultures in a food safety laboratory

GEA’s NiSoMate® becomes an essential compliance tool as EU waste directive comes into force
With the EU’s revised Waste Framework Directive now in effect, food and beverage manufacturers face new legal obligations to cut processing waste. GEA’s NiSoMate® delivers real-time, in-line quality control to help producers meet sustainability targets while reducing costly product losses.